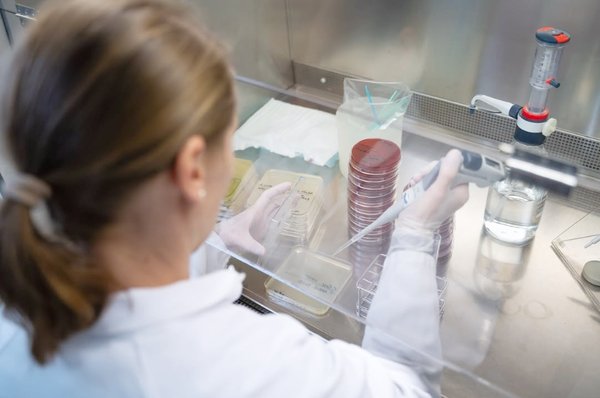
6659c807dd1923f0b6d9bfd0defe8e6949089336.jpg

Die Axon Biotech GmbH mit Sitz in Hengersberg in Niederbayern wurde 1999 gegründet und ist mit 45 Mitarbeitern seit über 25 Jahren als rechtlicher Inverkehr-bringer sowie als Lohndienstleister für Unternehmen aus Medizintechnik, Diagnostik und Pharma tätig.
Das Unternehmen wurde 2024 und 2025 zweimal in Folge als einer der wachstumsstärksten Mittelständler in Bayern ausgezeichnet, ist nach ISO 13485:2016 zertifiziert und verfügt über umfassende regulatorische Expertise gemäß IVDR. Neben der Produktion bietet Axonbiotech auch Laboranalytik mit Schwerpunkt Mikrobiologie an, um Kunden entlang des gesamten Produktlebenszyklus von der Idee bis zur Markteinführung zu unterstützen. Das Unternehmen hat derzeit drei Standorte, neben dem Hauptsitz in Hengersberg, eine Betriebsstätte Schwandorf in der Oberpfalz und in Nitra in der Slowakei.
Aktuell erweitert Axonbiotech seine Produktionskapazitäten um eine 1.000 m² große Lagerhalle sowie eine 300 m² umfassende Reinraumfläche am Standort Schwandorf. Damit schafft das Unternehmen optimale Voraussetzungen, um künftig noch größere und komplexere Projekte in den genannten Bereichen umzusetzen. „Mit der neuen Fläche können wir unsere Kunden noch besser unterstützen – von der qualitätsgesicherten Abfüllung und Montage bis zur Verpackung unter Reinraumbedingungen“, erklärt Herr Dr. Wolfrum, Geschäftsführer der Axonbiotech. „Unser Fokus liegt dabei klar auf dem Medizinproduktebereich sowie auf kundenspezifischen Lösungen in kleinen und mittleren Serien.“
Zum Leistungsportfolio des Unternehmens zählen:
- Abfüllung, Verpackung und Montage im Lohnauftrag
- Herstellung von Medien, Pufferlösungen und Reagenzien nach Kundenvorgabe
- Kommissionierung und Konfektionierung von Sets
- Mikrobiologische Prüfungen und Laboranalytik
- Unterstützung bei Validierung, Dokumentation und regulatorischen Anforderungen
Weitere Informationen: